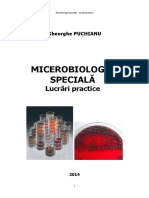

UNIVERSITATEA TRANSILVANIA din BRAOV
FACULTATEA DE ALIMETAIE I TURISM
Controlul i Expertiza Produselor Alimentare
Crnatul Cabanos
SSttuuddeennttaa::G
Ghheennaaddee E
Elleennaa--FFlloorreennttiinnaa
G
r
u
p
a
:
1
6
6
0
2
Grupa: 16602
A
Ann:: IIIIII
22001133
~1~
�C
CU
UPPR
RIIN
NSS
~2~
�Tema de proiect
Sa se proiecteze o secie de procesare a crnii pentru obinerea produsului finit
Carnatul Cabanos avnd capacitatea de procesare a seciei de 200 kg/or,iar materia
prim este carnea de vita si cea de porc.
~3~
�Capitolul [Link] teoretice
[Link] materiilor prime i auxiliare folosite la obinerea carnailor cabanos
Carne de vita calitatea I este reprezentat de buci de carne de mrime i forma
relativ uniforme,alese de grsime i esut conjunctiv care conin circa 6-8%esut gras i
conjunctiv vizibile,obinute,n principal din pulp i spat.
Carnea de vit calitatea Ieste utilizatpentru obinerea [Link] este o past de
legtur caracterizat prin adezivitate i vscozitate care asigur elasticitatea i suculena
preparatelor din carne.
Se obine prin tocarea mecanic fin a crnii,n special cea de vit,cu ajutorul utilajelor de
mrunire fin(cutere,maini de mrunit cu cuite i site,mori cocloidale).
Carne de porc lucru utilizat pentru obinera srotului.
Carnea de porc lucru se obine dup ndeprtatrea esutului conjunctiv,n special cel
lax,trebuie ndeprtat,deoarece n timpul pregtirii pastei se poate transforma ntr-un film
proteic care ngreuneaz pierderea de umiditate.
Standardele de calitate bazate pe compoziia chimic medie prevd pentru carnea de porc
lucru un coninut de ap de 53%,grsime 33%,proteine 9%(7% esut musccular i 2%esut
conjunctiv).
Carnea de porc lucru destinat srotului este prelucrat la volf.
Sarea i amestecurile de srare
Sarea este un ingredient esenial,avnd mai multe efecte asupra crnii i a preparatelor din
carne i anume:
-efectele tehnologice:creterea triei ionice i solubilizarea proteinelor cu consecine asupra
mbuntirii texturii produselor i a capacitii lor de legare a apei i a grsimii;creterea
capacittii de legare a produselor fin i grosier mrunite;
-efecte senzoriale:sarea este adugat,la niveluri diferite la produsele procesate,pentru
proprietile specifice de gust i pentru mbuntairea aromei altor ingrendiente;
-efecte de conservare:pentru majoritatea tipurilor de produse de carne sarea este utilizat i
pentru efectele ei de [Link] produsele procesate pe baz de carne srat ea acioneaz
sinergetic cu azotitul/azotatul,cu aciditatea mediului(pH-ul) i temperatura,efectul de
conservare fiind realizat n combinaie cu alte tehnici de conservare,cum ar fi
pasteurizarea,afumarea,fermentarea,uscarea i sterilizarea.
Agenii de srare, azotiii(nitriii) i azotaii(nitraii)au fost utilizai la srarea crnii iniial ca
impuriti prezente n sare,ca mai trziu s fie adugai n mod intenionat n formrile de
salamuri,semiconserve i la unele tipuri de conserve de carne.
Azotiii manifest efect asupra comportamentului microorganismelor i caracteristicilor
senzoriale ale preparatelor de carne prin:
-aciunea bacteriostatic i bactericid pe care o [Link] chiar n doye mici(80150) mg/kg previne dezvoltarea numeroaselor microorganisme i bacterii
patogene(Salmonella,Stafilococi);
-prevenirea germinrii sporilor de Clostridium botulinum;
-franarea produciei de toxin botulinic;
-controlul dezvoltrii bacteriilor n timpul procesrii i depozitrii:efectul azotitului asupra
duratei de pstrare sau prevenirea dezvoltrii bacteriilor patogene este dependent de
temperatura de depozitare i descrete cu creterea temperaturii de depozitare;
-inhibarea oxidrii grsimilor din crnuri i reducerea dezvoltrii rncezirii oxidative;
-formarea culorii specifice a preparatelor de carne:dezvoltarea culorii este realizat atunci
cnd pigmentul ( mioglobina) n mediu acid se combin cu oxidul de azot(NO,format din
azotit)pentru
a
forma
[Link]
reacie
este
afectat
de
temperatur,pH,agenii de [Link] este relativ rezistentla lumin
~4~
�i oxigen,dart devine stabil la tratament termic prin denaturarea termic a globinei din
structura pigmentului.
-dezvoltarea gustului caracteristic crnurilor srate cu adaos de azotit i componentele crnii.
Polifosfaii:efectele principale ale polifosfailor n sistemele de carne se manifest
asupra pH-ului,triei ionice,extraciei proteinelor miofribilare,legrii cationilor divaleni i
asupra vscozitaii.
Polifosfaii
utilizai
n
industria
crnii
sunt:tripolifosfatul
de
sodiu;hexametafosfatul;pirofosfatul de sodiu;fosfatul acid de sodiu;fosfatul monosodic.
Acceleratorii de srare cum sunt acidul ascorbic/izoascorbic sunt utilizai pentru a
grbi procesul de srare prin transformarea mai rapid i complet a azotitului.
Zahrul are rolul de a mbunti gustul preparatului de carne i de a favoriza
formarea nitrozopigmenilor.
Condimentele acioneaz asupra glandelor salivare i digestive pentru a promova
secreia,stimularea apetitului i pentru a mbunti digestibilitatea produselor din [Link]
fabricarea crnailor cabanos se folosesc urmtoarele condimente:
a)Usturoiul(Alium sativum) se folosete n industria crnii sub forma de pudr sau
form uscat i se pstreaz n depozite uscate,aerisite i ferite de nghe.
Mirosul i gustul iute al usturoiului se datoreaz uleiului eteric pe care-l conine n
proporie de 0.005-0.009%.Este adugat pentru efectul bacteriostatic.
b)Coriandrul(Coriandrum sativum) seminele plantei se utilizeaz ca i condiment
fiind bogate n uleiuri eterice.
c)Piperul negru(Piperum nigrum)se folosec fructele uscate de culoare neagr,sub
form de pudr sau [Link] de piper conin un alcaloid,numit piperin,care confer
gustul picant,iute.
Izotatul proteic din soia este forma cea mai rafinat a derivatelor proteice din
soia,fr glucide solubile n ap i alte componente [Link] coninutului lor ridicat
n proteine (aproximativ 90%),ele au proprietti excelente de dispersare,emulsionare
,gelificare,de legare a apei.
Pigment de snge din snge integral pentru obinerea pigmentului rou de
snge,concentratul eritrocitar se hemolizeaz prin adaos de ap, se stabilizeaz prin adaos de
ascorbat de sodiu i NaNO2 i se conserv prin frig(refrigerare,congelare).
Apa se adaug pentru mbuntirea consistenei amestecului i susulenei
produselor,dozolvareaunor ingrendiente i asigurarea transportului acestora;controlul
temperaturii la cuterizare i [Link] se adaug i se folosesc sub
form:lichid,solid(fulgi de ghea),vapori la tratamentul chimic.
Materiile auxiliare:
1. Membranele: sunt nveliuri naturale sau artificiale n care se introduce compoziia
pentru a-i da o anumit form, pentru a micora pierderile n greutate i a preveni alterarea
[Link] cazul carnatilor cabanos se folosesc membrane [Link] naturale
reprezint poriuni din tractusul intestinal de bovine, porcine sau ovine care se deosebesc
ntre ele prin lungime, diametru i rezisten. Membranele naturale se conserv prin uscare i
srare i trebuie s corespund urmtoarelor cerine: s provin de la animale sntoase; s fie
strnse n legturi (cele srate) sau pachete (cele uscate); s fie bine degresate; s nu prezinte
miros de rnced, acru (fermentaie) sau putred; s nu prezinte ferestre (locuri cu pereii
subiai) sau guri. nainte de a fi folosite, membranele naturale pot fi tratate cu o serie de
substane antimicrobiene, cum ar fi: acizi: lactic, acetic, tartric, citric i srurile alcaline ale
acestora; acid ascorbic n amestec cu oetul; ap oxigenat i hipoclorit (ap de Jovel),
pimaricin, antibiotic solubil n ap.
Se folosesc pentru carnaii cabanos mae subiri de oaie cu diametru de 16-20 mm.
~5~
�2. Sfoara: dupa introducerea compoziiei in membrane se folosete sfoara 2C pentru
[Link] se pstreaz n spaii cu umezeal relativ de cel mult 14%.La crnai se
execut rsucirea manual sau mecanic n buci scurte.
3. Rumegusul: necesar pentru producerea fumului utilizat la afumarea cald si rece.
Rumeguul este pastrat in depozite uscate si ferite de umezeal.
Pentru a se obine un fum bun, trebuie ca arderea lui sa se faca uniform, iar gradul de
marunire sa fie 1 mm, lemnul preferat fiind cel de fag.
[Link] de la care provin materiile prime necesare fabricrii crnailor cabanos.
Bovinele:
Rase de bovine crescute in Romania:
1)rase de lapte: Holstein
Aceast rasa de vaci se trage din populaile de vaci locale din nord-estul Scoiei, iar
imbunatatirea acesteia a inceput de la jumatatea secolului al 18 [Link] bovine sunt
caracterizate printr-o talie mijlocie cu valori de 127 - 135 cm la vaci si 136 144 cm la tauri;
o greutatea este de 800 1000 kg la tauri si 550 700 kg la [Link] poate observa foarte bine
masivitatea pronunat a corpului cu musculatura foarte dezvoltat i constitutia [Link]
natere viteii au o greutate de 30-35 kg. Ftrile se desfasoar far probleme cu un procent de
98,6 % ftri [Link] se narca la vrsta de 8 10 luni, iar ntreaga cantitate de lapte de
la vaca mama este destinat pentru hrnirea [Link] taurin supus ingrrii
realizeaz sporuri medii zilnice de 1000-1300 g, ajungnd la varsta de 15-16 luni la greutatea
de 450-500 [Link] ridicat la sacrificare de peste 60%, iar la tineretul foarte bine
ingraat intre 67 - 72%, cu raportul de carne - oase mai mare de 5:1, longevitate, usor de
ngrijit i foarte adaptabil la diferite condiii de mediu.
Balat Romneasc
~6~
�Este o ras de bovine mixta cu aptitudini atat pentru carne ct i pentru lapte care s-a
format in nord-estul rii, Transilvania si [Link] de formare a inceput in anul 1860,
prin ncruciarea vacilor rasei locale Sura de stepa cu tauri din rasa Simmental originari din
Elvetia, dupa care Austria i Germania, pana la absorbia completa a rasei [Link]
exterior se aseamn cu rasa din care provine, Simmental, dar are i caractere care o
deosebesc ca [Link] robei este un caracter de ras si este formata din baltauri galbene,
de diferite nuane, de la galben deschis pana la rosu, dispuse pe un fond de culoare alba.
Capul i extremitile sunt de culoare alba, oglinda botului de culoare roz deschis, iar
coarnele i ongloanele sunt [Link] o constituie robust, un temperament linitit si
caracter blnd, talia cuprinsa intre 130 145 cm si greutatea corporala de 500 700
[Link] are limite foarte mari, fiind cuprinsa intre 2500-6500 kg lapte, cu vrfuri de
pana la 8000 kg lapte, cu un procent de grasime de 3,7-4,5%.Tineretul taurin ngrasat
realizeaz greutati vii de 460 560 kg la varsta de 18 luni, cu un spor mediu de 850 1100 g
si un randament la sacrificare intre 53,6 57,9%.
Porcine
Principalele rase de porcine dup raportul carne/grsime:
-Rasele pentru carne:Au corpul cilindric,bot alungit.,o musculatur bine dezvoltat.,
sunci [Link] la o greutate corporal de 100-120 kg.n 8-10 [Link] randament ridicat la
tiere.
Rase :Marele alb, Marele negru,etc.
-Rase pentru grsime: Au corpul n form de [Link] scurt i gros, bot scurt, urechi
lungi.
Rase: Mangalia
-Rase
mixte:
Au
caractere
intermediare
dintre
primele
dou.
Rase :Porcul de Bazna,Negru de Strei
Marele Alb
~7~
�Este o rasa de porci de talie mare, specializata pentru obtinerea de carne, avand capacitate
remarcabila de productie de carne, la 1 an 140 kg, totodata si prolificitatea mare in medie 12
purcei la fatare, iar ca si record de purcei obtinuti la o fatare 30 de purcei. Corpul la Marele
Alb este lung, capul mare, profil concav, urechi mari si purtate in sus si inainte, spatele drept,
corpul cu masa musculara bine reprezentata, schelet solid si membre rezistente, mers
elastic. Pielea de culoare alb-roz, posibil si pigmentatii reduse ca suprafata, sensibili la
actiunea razelor solare fata de care daca nu sant protejati se produce eritem si intarzieri in
dezvoltare, cu repercursiuni economoice.
Marele Negru
Marele Negru este o rasa de statura mare si intotdeaua de culoare neagra. Porcii din
aceasta rasa au capul mare si drept, cu urechi lasate. Au o buna adancime a corpului, o
lungime rezonabila si un spate puternic. Parul este fin si mai degraba subtire, puternic
pigmentat
in
negru.
Urechile foarte lasate sunt si o carcateristica a rasei. De fapt, urechile sunt atat de mari incat
acopera mare parte a fetei si pare sa-i obstructioneze vederea. Rasa este cunoscuta pentru
natura sa docila, iar unii au sugerat ca faptul ca ii este obstructionata vederea a contribuit la
temperamentul sau neagresiv. Oricare ar fi cauza, acesti porci par sa se miste mult mai incet
si deliberat, comparativ cu alte [Link] aceasta rasa se spune ca ar avea un nivel ridicat
de forta si cumpatare. Pe de alta parte, rasa nu pare sa se maturizeze la fel de bine ca alte rase.
In plus, culoare neagra este o caracteristica nu foarte apreciata de procesatori.
Mangalia
~8~
�Rasa de porci Mangalita este una dintre cele mai apreciate rase n Europa datorit
crnii gustoase i parselate pentru care este crescut animalul. Cu un nas fragil i crn, cu
prul cre blond sau roscovan, doar pulpele lungi i lipsesc acestui porc grsun. n rest e
numai bun de untur i crnciori.
Datorit prului sau lnos i cre, amintete de un miel, ce-i drept, unul mai murdar i mai
mare.
Trupul i este acoperit uniform cu pr cre care poate avea 4 culori diferite:
blond,
gri,
negru (care a disprut n prezent! ) i
rocat.
Are capul mic, urechile uriae care atrn n fa. Are un gt mare i ceafa lat, cilindric
i scurt. Trunchiul este potrivit de lung, spatele musculos, solid. Pieptul este adncit,
burt mare (trstur specific porcinelor!) i picioarele scurte.
~9~
�Capitolul 2. Aspecte tehnologice
2.1. Descrierea fluxului tehnologic de obinere a carnailor cabanos
Reteta de fabricare pentru 200 kg materie prima:
-carne de vita calitatea I: 32kg
-carne de porc lucru: 168kg
Condimente:
-usturoi 0,600kg sau arom de usturoi 0,16 kg
-coriandru 0,30kg
-condiment universal 0,4 kg
Adaos:
-pigment de snge din snge integral 0,50kg
- izolat proteic din soia 8 kg
Material auxiliare:
-mae subiri de oaie cu diametrul de 16-20 mm
nainte de inceperea procesului de fabricaie a crnailor are loc depozitarea i maturarea
semifabricatelor(bradt si srot): bradtul i rotul se depoziteaz n ncperi rcite la temperaturi
cuprinse ntre 0 - 4C, ale cror dimensiuni se stabilesc n funcie de sistemul adoptat pentru
maturarea semifabricatelor. La nivel industrial se utilizeaz urmtoarele tipuri de recipiente:
tvi cu picior, cu o capacitate de 25 kg, care se aeaz prin suprapunere cte 6 - 8 pe nlime;
tvi fr picior, cu capacitatea de 25 kg,care se aeaz pe rastele crucior (cte 6 pe nlime);
recipiente pe roi cu o capacitate de 250 kg carne. ntre stivele de tvi sau iruri de crucioare
se las spaii de circulaie cu limea de cel puin 11/2 limea mijlocului de transport.
Semifabricatele din grupa saramuratelor se depoziteaz n ncperi rcite n bazine de oel
inoxidabil cu capacitatea de 500, 1000 sau 2000 [Link] depozitarea semifabricatelor de tip
bradt i rot se continu hidratarea prin uniformizarea apei de hidratare sau a saramurii i se
continu proteoliza cu o intensitate diferit n funcie de temperatura de depozitare, de
microflora existent i enzimele proprii crnii (maturarea bradtului i rotului). n timpul
depozitrii are loc nroirea crnii, nregistrndu-se totodat pierderi n greutate datorit
evaporrii apei de la suprafaa recipientelor deschise cu bradt sau rot. Depozitarea rotului se
face pentru 24 ore, dac crnurile au fost srate cu amestec de srare rapid n proporie de
2,6% sau 48 - 72 ore dac au fost srate cu amestec de srare lent. Maturarea bradtului n
condiii de igien superioare i n flux continuu se poate realiza n maturatoare fixe i
rotative.
Procesul tehnologic conine urmatoarele faze:
Prepararea compoziiei
Carnea de vita calitatea I se prelucreaz pentru obinerea bradtului. La prepararea bradtului se
adaug condimentele mcinate, pigmentul din snge, unul din derivatele proteice i apa de
hidratare aferent.
Dac derivatul proteic a fost adaugat la malaxarea crnii, n timpul prelucrrii bradtului se
adaug doar apa de hidratare a acestuia.
rotul se realizeaz din carnea de porc lucru care se marunete prin sita cu ochiuri de 8 mm.
Componentele astfel pregatite se malaxeaz mpreuna pn la omogenizarea compoziiei.
Umplerea compoziiei n membrane
~ 10 ~
�Compoziia se umple n membranele naturale: mae de oaie cu diametrul de 16-20mm.
Membranele se rsucesc la 40-50cm formndu-se bucai n irag.
Afumarea cald
iragurile de crnai aranjate pe bee i aezate pe rstele se introduc n afumtorie sau
n celulele de [Link] se aeaza pe bee cu spaii intre ei astfel ncat
afumarea sa se fac [Link] incepe cu zvntarea membranelor la temperatura de
45-75C, dup care se face afumarea cald propriu-zis la temperaturi de 75-95C, pn cnd
membrana produsului capt o culoare brun-deschis.
Tratamentul termic n ap sau abur
Dupa afumarea cald, crnaii se introduc n cazane cu ap sau se continua tratamentul termic
in celulele de [Link] termic n ap sau abur se face la temperatura de
72-75C timp de 15-20 minute pn cnd centrul geometric al produsului atinge temperatura
de 68-69C.
Afumarea II
Dup tratamentul termic n ap sau n abur produsul se afuma din nou, la fum cald, la
temperatura de 75-95C pn cnd membrana capat o culoare rou-brun.
Depozitarea
Se depoziteaz n camere frigorifice uscate i bine ventilate, la 10C-12C pn la realizarea
umiditii [Link] depoziteaz pe bee aezate pe rstele, cu spaii ntre iraguri de 5-7cm,
pentru a permite circulaia aerului i uscarea ct mai uniform.
Schema tehnologic de obinere a Crnatului Cabanos
~ 11 ~
�Recepie
Condimente
Carne vita cal I
Carne porc
Pigmeni de
Izolat
Mae
lucru
snge
proteic
oaie
de soia
Depozitare
Macinare
Tocare sit
Tocare sit
de 3 mm
de 8 mm
Malaxare
Umplerea compoziiei in
membrane
Amestec de sarare
Rasucire
Afumare cald I
Tratament termic in
ap sau abur
Afumare II
Depozitare
Livrare
~ 12 ~
�2.2 Bilan de materiale:
[Link] :
Paf2
Paf2=produs afumare 2
Depozitare
Pd=produs depozitat
P1
p1=pierderi la depozitare
Impunem P1=0.25%
Pd
Paf2=Pd+P1
Paf2-0.25/100*Paf2=200
P1=0.25*Paf2
Paf2=200+0.25/100*Paf2
Paf2(1-0.25/100)=200
Paf2=200/0.997=200.601kg
[Link] 2
Pf=produs fiert
Pf
Paf2=produs afumare 2
Afumare 2
P2=pierderi la afumare 2
Pf=Paf2+P2
Paf2
Pf=Paf2+10/100*Pf
Pf(1-10/100)=200.601
Pf=200.601/0.9=222.89 kg
~ 13 ~
P2
�~ 14 ~
�Capitolul [Link] folosite pentru obtinerea cabanosului
[Link] de tocat de tip Wolf
Main de tocat de tip volf-SEYDELMANN
Proprietai:
-are o capacitate de aproximativ 400 litri
-este facut din oel inoxidabil solid
-
~ 15 ~
�[Link]
Aparat de malaxat-Seydelmann
Proprieti:
-are o capacitate de aproximativ 985 litri
-capacitatea de malaxare de aproximativ 200-550 kg(depinde de produs)
-este facut aproximativ tot din oel inoxidabil
-2 axe de amestecare,schimbndu-se independent,nainte si napoi,lucrnd lent i rapid
-2 motoreductoare,fiecare avnd 2,6/3,2 kw
-afiaj digital in carcas de inox separat pentru preprogramarea
intervalelor(schimbarea nainte i napoi) i timpul total de malaxare
-2 prize de dozare cu o clapa comuna de descrcare,operat pneumatic
-piedestal de operare din oel inoxidabil solid pe partea dreapt
-4 picioare de cauciuc pentru nlimea carucioarelor standard,BW 200.
~ 16 ~
�[Link] de umplut cu funcionare continu
Masina de umplut-Handtmann
Sistemul Handtmann Vf 611 pentru umplere continua reprezinta masina de umplere
perfecta pentru sistemul AL FPVLH 242. La o presiune constanta, sistemul asigura o
umplere continua si un flux continuu de produs finit si garanteaza o lungime constanta (pentru
carnati).
Avantaje
Comanda compacta cu monitor ( 10 `` color, Windows-CE), cu memorie de programe.
Fluxul constant asigura un produs de o calitate constanta.
VF 611 se conecteaza usor la FPVLH 24.
Pistonul optional de compensare a greutatii aduce avantaje noi in ceea ce priveste
portionarea, iar surplusul de materie prima este redistribuit la o viteza constanta.
Specificatii tehnice
Capacitate de umplere: 4800 kg/ora.
Presiune de umplere: pana la 15 bar.
Palnie de capacitate variabila de 90/240 litri (standard) sau 40/100 litri (optional).
~ 17 ~
�[Link] de fierbere i afumare KERRES anlagensissems
Proprietati
-prietenos cu mediul, economic si usor de operat
-generator de fum automat
-uscare, prajire, maturare, fermentare and coacere
-proces controlat de microprocesor
-disponibil in diferite marimi si cu in diferite variante de incalzire
-disponibil de asemenea pentru sisteme de transport suspendate.
-constructie din otel-inoxidabil si conforma standardelor de igiena
CE.
-usor de curatat datorita sistemului integrat de curatare cu spuma.
-operatiuni posibile: afumare la cald, afumare la rece, afumare
intensiva
~ 18 ~
�~ 19 ~
�~ 20 ~
�~ 21 ~
�~ 22 ~
�~ 23 ~
�~ 24 ~
�~ 25 ~
�~ 26 ~
�~ 27 ~
�~ 28 ~